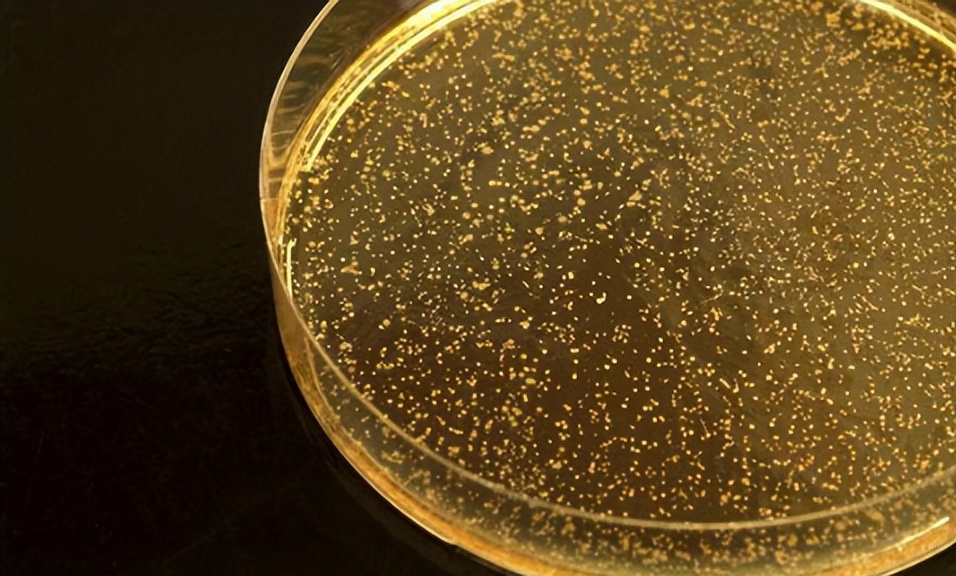
大白菜乳酸菌发酵,白甘蓝与紫甘蓝
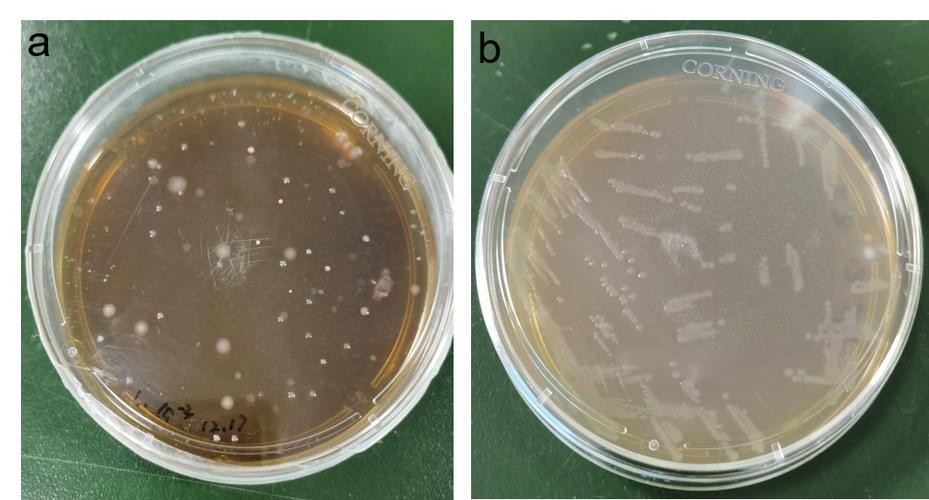
大白菜乳酸菌发酵,白甘蓝与紫甘蓝

前言
芸苔属蔬菜富含纤维、矿物质和生物活性化合物。乳酸发酵可以提高其营养价值,本研究的目的是评估白甘蓝、红甘蓝和大白菜自该研究以水提取物、甲醇提取物和盐水为特色, 该过程涉及在卷心菜发酵过程中监测乳酸菌和pH值。

采用二苯基-1-三硝基肼清除法(DPPH)清除法和铜还原抗氧化能力法(CUPRAC)法测定抗氧化活性,采用Folin-Ciocalteau法测定水和甲醇提取物中的总酚含量, 在盐水样品中,我们研究了钙、植酸和植酸酶活性。

白菜和红甘蓝样品在第5-10天表现出最高的植酸酶活性,植酸降低幅度最大,钙浓度增加最大, 而在大白菜中,这些过程在整个发酵过程中逐渐发生,在整个发酵过程中, 所有品种的盐水和提取物中的总酚含量非常相似。

在发酵的前十天可以观察到从固相到盐水的持续释放。DPPH和CUPRAC测定显示总酚含量存在类似的现象,水和甲醇提取物中的抗氧化能力降低,盐水中的抗氧化能力增加,发酵结束时,红甘蓝样品的总酚含量和总抗氧化活性显著增加, 在大白菜中表现较不明显。相反,白甘蓝样品显示出这些参数的减少。
发酵可以提高白菜、红甘蓝和大白菜中游离钙的浓度, 并提高红白菜和大白菜的抗氧化能力。

实验目的和过程方法
芸苔属蔬菜的浓度低蛋白质和脂肪,使它们受欢迎的低热量食品, 此外,它们富含纤维,如矿物质如钙和铁,以及诸如多酚和硫代葡萄糖苷,钙是必不可少的用于人类饮食,乳制品是钙,无论是定性还是定量。

然而乳糖不耐症患者和素食主义者避免乳制品,使芸苔属蔬菜成为推荐每日钙的极好来源摄取。事实上,卷心菜含有高浓度的钙、铁、硒、铜、锰和锌。不幸的是, 它还含有可能形成的植酸盐与钙的络合物,从而降低其生物利用度和营养价值。

食品安全和保质期与微生物竞争与抑制物的合成代谢物, 如乳酸、乙酸、氢过氧化物、双乙酰、乙醇、细菌素和生物表面活性剂。 乳酸发酵改善营养卷心菜的价值,以及它的抗氧化活性。乳酸发酵可减少植酸盐,从而改善必需膳食营养素的生物利用度, 例如作为矿物质,例如钙2+锌2+毫克2+锰2+和铁2+/3+,蛋白质和氨基酸。
不同的数据库具有相同的营养成分 芸苔属蔬菜数据(能量、脂肪、蛋白质、矿物质含量和碳水化合物),然而, 当涉及到内容时,情况就大不相同了生物活性化合物。
轮廓和浓度的植物化学物质取决于品种,施肥,农业条件,环境,播种季节,和处理方法, 不同的研究报告发酵对总量的不同影响酚类化合物和抗氧化活性,到目前为止,还没有研究将以下变化纳入其中产生的总酚类物质和抗氧化活性在卷心菜组织和盐水之间。

研究目的是评估效果自发发酵:1)植酸酶活性,钙和植酸浓度;2)总酚类甲醇提取物含量及抗氧化活性,整个发酵过程中的水提取物和盐水在巴塔哥尼亚收获的三种芸苔科卷心菜。

研究对象和方法
大白菜(芸苔属)拉帕变种光头雷格尔),白甘蓝(芸苔属)白菜和红甘蓝(B.oleracea var. capitata f. rubra)获得自位于丘布特河谷的当地农场在阿根廷巴塔哥尼亚, 种植卷心菜2020年2020月收获,2年3月收获。在发酵,每个卷心菜头被剥去干外叶。
洗净的卷心菜头被切碎在粉碎机中切成0毫米厚的条状并与5.100%盐。无菌水均质化培养基(18mL/30g卷心菜),每个卷心菜都自发发酵,这发酵一式两份进行。

结果和讨论
乳酸菌和pH值有助于监测发酵的演变过程, 卷心菜的自发发酵依赖于关于原始存在的本土乳酸菌酶作用物, 有机酸降低pH值并增加原料的可滴定酸度。
生白甘蓝、红卷心菜和大白菜分别为6.0、5.9和6.1,红白菜和大白菜的样本表现出类似的pH值降低,在这两个品种中,在第4天观察到最低值并保持稳定超过30天, 白甘蓝发酵过程中pH值未急剧下降。在第10天达到最低值并保持稳定。

乳酸菌的初始种群是2.1、2.1和2.5logCFU/mL白色、红色、和大白菜, 这趋势证实了R.DiCagno等人之前的报道,虽然在第5天观察到最高计数(9.9logCFU/mL),接近红甘蓝样品第3天的最大计数(9.4logCFU/mL)。

之后也观察到了类似的曲线卷心菜发酵; 但是,最大值计数在第4天(9.7logCFU/mL)后检测到关于白甘蓝,乳酸菌种群增加速度比其他样品慢,并达到其最大值(9.2logCFU/mL)在第5天。
在所有情况下,一旦达到峰值,细菌开始减少。 第30天,乳酸细菌细胞计数分别为5.0、5.9和5.7logCFU/mL。
钙、植酸和植酸酶活性
研究 显示了植酸酶活性的变化和钙和植酸浓度发生在发酵过程中的盐水,红色的原始样品和大白菜含有相当量的水溶性钙, 而白菜似乎有很多较低的浓度。

植酸的初始水平几乎相同对于所有三个品种,中文原料卷心菜显示出最高的植酸酶活性,白甘蓝和红甘蓝的初始具体活动分别为39.54±18.67和56.71±8.20mU, 酶活性为发酵初期完全由植物组织供给,再由细菌植酸酶带来植酸盐水解。
在白甘蓝和红甘蓝样品中的第5天和第10天,当乳酸菌的数量达到其最大值, 之后保持不变 ,在大白菜的样本中,在第10天检测到最大活性,这与最大活细胞计数乳酸菌。

随着发酵过程的推进,植酸盐浓度降低,量所有样品中的可溶性钙增加,这大白菜现象更为明显当植酸酶活性具有最高值时, 这植酸盐浓度最低,钙含量最高在第30天达到集中 ,的检测所有样品都证明植酸酶活性最高在酸性条件下发生。

植酸(肌醇-6-磷酸)是主要的磷的储存形式,占50-85%植物中的总磷,这种化合物其衍生物是二价的主要*制剂抑**由于胃肠道中的矿物质吸收形成不溶性和难以消化的复合物, 因此,它可能会降低钙的生物利用度在卷心菜。
然而,这种观点现在是有争议, 因为几项研究表明肌醇-6-磷酸的消耗量可能与一些健康益处有关。抗营养素植酸的作用尚未在体内得到充分证实,另一方面, 植酸发挥抗炎和抗癌活性,减少骨质疏松症的风险。

抗氧化活性
抗氧化活性通过DPPH自由基清除试验进行评估, 并库普拉克还原测定。两者都是基于电子转移的方法,通常用于确定酚类化合物的抗氧化活性,研究显示了甲醇的抗自由基活性和水提取物对抗DPPH自由基。

甲醇提取物的还原力明显低于所有卷心菜样品中的水提取物,可能该溶剂无法提供有效的萃取具有抗氧化活性的化合物, 红甘蓝原料样品的抗氧化剂含量最高容量为1050.44±71.33TE/100gDW和616.63±49。 80mgTE/100gDW的水和甲醇溶液分别提取, 之后,这些值下降直到发酵结束。

相反,在盐水中,数值不断上升直到第5天,然后保持稳定,摘录白菜和大白菜表现出显着DPPH自由基清除活性低于提取物红甘蓝(图4a和4c), 这些趋势得到了证实以前的报告, 甲醇和水提取物的白甘蓝表现出略有下降抗自由基活性,而其盐水显示出在发酵的前5天内增加, 然而,抗氧化剂没有显着差异在大白菜提取物中观察到活性。 在盐水中检测到显着增加发酵的前10天,但它仍然存在恒定直到发酵结束。

在所有情况下,抗氧化能力的值用CUPRAC测定获得的,高于用DPPH方法获得的那些, 这种趋势可能是通过CUPRAC方法的测量能力来解释亲水性和亲脂性抗氧化剂同时存在, 而DPPH仅检测那些溶于有机溶剂,特别是醇类。

红白的抗氧化能力卷心菜在甲醇中的含量显著减少, 第1天水提取物显著增加在盐水中,在白菜里, 这些变化发生在第5天和第10天之间, 对于红甘蓝,在第5天观察到减少甲醇提取物和第15天在水中提取。5天后达到盐水的最大值。

关于大白菜样品,一个在通过DPPH自由基清除测定获得的值和库普拉克方法, 浓度还原干物质中的药剂在水中缓慢减少提取物, 而甲醇提取物未显示显著性差异, 略有但显著增加在盐水中检测到浓度。
抗氧化能力急剧增加在第1天, 这种趋势是由于由浓度梯度产生的驱动力倾向于平衡介质的物质,在此工艺过程中,水从固相流向液体相,并从蔬菜中带来一些溶质, 这现象是由于传输速率增加或减少直至达到平衡。

总酚类物质和抗氧化活性
总酚含量和白甘蓝和红甘蓝的抗氧化活性样品在干物质中减少,在液相。这种现象在大白菜样本,然而,仅 这些数据无法估计抗氧化剂的总变化整个过程的能力: 两个阶段都做出了贡献, 发现对酚类含量和清除活性自卷心菜不能吃。
显示了通过添加获得的结果干物质和盐水的值, 这些结果可以考虑总多酚含量和发酵卷心菜的总抗氧化活性,关于红白菜和大白菜的样品,总酚含量和总清除活性在水中提取物和盐水逐渐增加和大约5-10天后达到高原,这恰逢乳酸菌数量最多。

在白甘蓝样品,总酚含量和水提取物中的总抗氧化能力和液相表现出轻微的变化,到最后发酵, 总酚含量和抗氧化活性相似或更小, 在这种情况下DPPH测量的自由基清除活动。
综上所述,发酵增加了总数酚类含量和抗氧化活性在红白菜和大白菜的液相, 红色的卷心菜样品的总酚含量最高。

结论
发酵能够显着改善 芸苔属卷心菜的质量和功能, 这测试样品显示植酸酶显着增加活性,促进植酸减少以及游离钙的增加, 发酵提高总酚含量和抗氧化活性由于个人贡献的固体和液相占总清除能力。

参考文献
[1]李海,吴一恩,《酚类化合物谱及其在新的红色表型头部形成大白菜中的季节性变化》
[2]潘迪,里兹维,《植物多酚作为人类健康和疾病的膳食抗氧化剂》
[3]胡思杰,李思,《发酵对植物性食品抗氧化活性的影响》
[4]艾利斯,费尔南德斯《对六种经济上重要的芸苔属蔬菜的生物活性化合物和抗氧化能力的季节性影响》